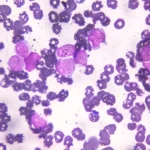

Qu’est-ce que la leucémie lymphoïde chronique ?
La leucémie lymphoïde chronique est un type de cancer du sang qui affecte les cellules lymphoïdes, responsables de la production des lymphocytes. Elle se caractérise par une multiplication anormale et incontrôlée de ces cellules dans la moelle osseuse, le sang et les ganglions lymphatiques. La maladie progresse lentement et peut rester asymptomatique pendant de nombreuses années. Les symptômes les plus courants incluent une fatigue persistante, des ganglions lymphatiques enflés, une perte de poids et des infections fréquentes. Le traitement de la leucémie lymphoïde chronique peut inclure une surveillance active, une chimiothérapie, une immunothérapie ou une greffe de moelle osseuse, en fonction du stade de la maladie et de la santé globale du patient.
Quels sont les symptômes d’une leucémie lymphoïde chronique ?
La leucémie lymphoïde chronique est un type de cancer du sang qui affecte les lymphocytes, un type de globules blancs. Les symptômes de cette maladie peuvent varier d’une personne à l’autre, mais certains signes courants incluent :
- Fatigue persistante
- Gonflement des ganglions lymphatiques
- Perte de poids inexpliquée
- Sueurs nocturnes
- Infections fréquentes
- Anémie
- Augmentation de la taille de la rate ou du foie
Ces symptômes peuvent être causés par la multiplication incontrôlée des cellules cancéreuses dans la moelle osseuse et le sang. Il est important de consulter un médecin si vous présentez ces signes, car un diagnostic précoce peut améliorer les chances de traitement et de survie.
Quelles sont les causes d’une leucémie lymphoïde chronique ?
La leucémie lymphoïde chronique (LLC) est une maladie complexe dont les causes ne sont pas entièrement comprises. Cependant, plusieurs facteurs de risque ont été identifiés, notamment des facteurs environnementaux et génétiques. Les individus exposés à certaines substances chimiques, comme les pesticides, peuvent avoir un risque accru. De plus, des antécédents familiaux de cancer ou de maladies sanguines peuvent également jouer un rôle. Voici quelques causes potentielles :
- Facteurs génétiques
- Exposition à des produits chimiques
- Âge avancé
- Antécédents médicaux
Diagnostic d’une leucémie lymphoïde chronique
Le diagnostic de la leucémie lymphoïde chronique (LLC) repose sur plusieurs étapes clés. D’abord, une analyse sanguine est effectuée pour détecter des anomalies dans le nombre et le type de globules blancs. Ensuite, une biopsie de la moelle osseuse peut être réalisée pour confirmer la présence de cellules leucémiques. Des examens d’imagerie peuvent également être utilisés pour évaluer l’étendue de la maladie. Enfin, des tests génétiques aident à déterminer le pronostic et le traitement approprié.
- Analyse sanguine pour anomalies
- Biopsie de la moelle osseuse
- Examens d’imagerie
- Tests génétiques
Traitement d’une leucémie lymphoïde chronique
Le traitement de la leucémie lymphoïde chronique (LLC) dépend de plusieurs facteurs, notamment de l’état de santé général du patient et de l’évolution de la maladie. Les options thérapeutiques incluent souvent des chimiothérapies, des thérapies ciblées et des traitements immunologiques. Dans certains cas, une surveillance active peut être recommandée si les symptômes sont légers. Il est essentiel de discuter des choix de traitement avec un hématologue pour déterminer la meilleure approche adaptée à chaque patient.
- Chimiothérapie
- Thérapies ciblées
- Immunothérapie
- Surveillance active

S.N. est un rédacteur spécialisé dans la santé, travaillant sur le site Doqi.fr, un site d’annuaire et d’actualités axé sur les sujets liés au coronavirus.